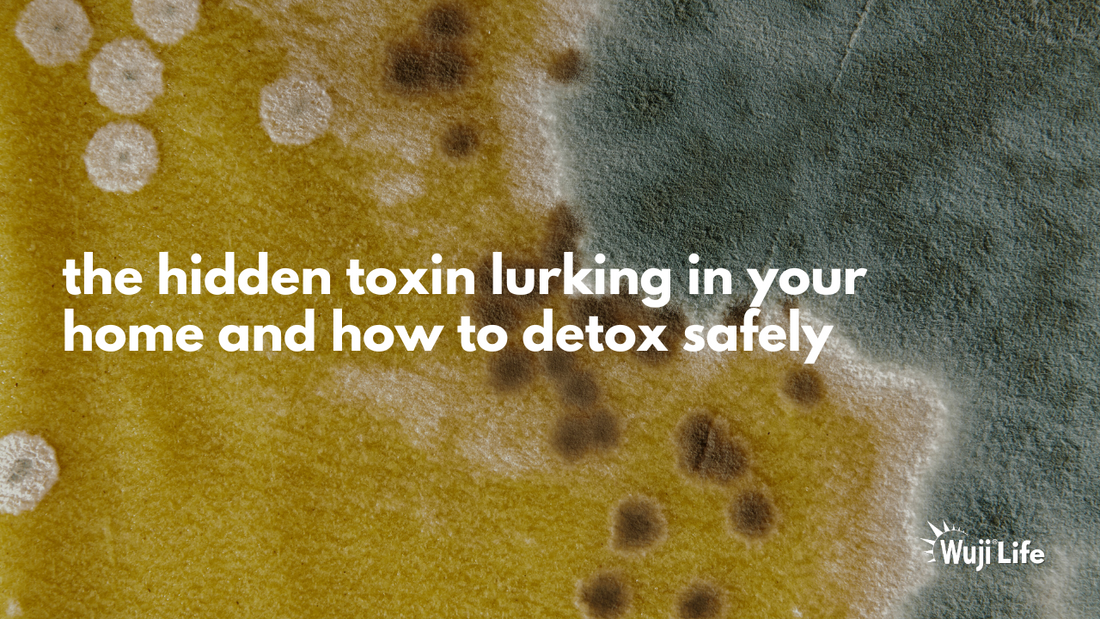

The Hidden Toxin: Reclaiming Your Space and Health from Mold
By: Wuji Ninja, Mary Lambdin, MSACN, CNS candidate
This might come as a relevant surprise that in a 2022 study, 47% of homes were reported to have a mold problem. Moreover, 70% of homes are likely to have a degree of mold present in them. The three states with the highest rates of illness due to mold exposure are Kansas, New York, and New Jersey. The three states with the lowest rates of illness due to mold exposure are Hawaii, Nevada, and Washington.

Symptoms of mold exposure may look like chronic sinus infections, allergies, asthma, and other immune dysfunction not otherwise unexplained. Mold exposure over time may lead to mycotoxicity which includes a plethora of different challenges. This may look like brain fog, joint stiffness and pain, cognitive decline, irritable bowel syndrome/disease (IBS/IBD), headaches, fatigue, and mental health challenges (i.e. depression, anxiety, ADHD, OCD), to name a few.
 Treating mycotoxicity involves several different efforts to ensure that you’re living mold-free.
Treating mycotoxicity involves several different efforts to ensure that you’re living mold-free.
1. The first step is remediation – remediation is the process of having an air quality specialist assess for the presence of mold, and then have a well-qualified team come in and rid the premises of mold. A tip for success would be to consider an alternative, mold-free dwelling if remediation efforts take longer than expected OR are unachievable at that given moment.
2. The second step is detox – detoxifying the body of mold is necessary to allow the body space for regeneration. Please note that when detoxifying the body, toxins typically get “freed” within the body, leaving opportunity for reabsorption if not properly detoxified. To ensure proper Phase I, II, and III detoxification, offer support to the liver and gut by strengthening detox pathways and in addition to Chlorella, use a strong, binding agent to fully extract toxins from the system. Studies suggest that the following chelating agents are supportive for binding to toxins:
o Zeolite
o Activated Charcoal
o Bentonite Clay
o Humic Acid and Fulvic Acid

The final step is support – supporting the body through this process is imperative. Mycotoxins cause an inflammatory reaction in the body by “tricking” the cell into believing it is a binding molecule. This process is called cytotoxicity and can result in either cell death and/or damage. For this reason, combatting inflammation and oxidative stress is essential. In addition to integrating more anti-inflammatory, antioxidant rich foods into the diet, here are a couple anti-inflammatory and antioxidant supplements to consider:
o Curcumin
o Resveratrol
o NAC
o Green Tea
o Glutathione
o Omega-3 Fatty Acids
o CoQ10

Above all, the best thing to do when dealing with mold exposure/mycotoxicity is to place time and effort into truly taking care of yourself. Take yourself to the sauna to further release toxins through sweat, do some gentle yoga to promote lymphatic drainage, and prioritize fruits and vegetables to feel well-nourished. Practicing stress management strategies such as meditation, breathwork, walking, and social connection can also provide some much needed relief during what can be a very tumultuous experience. If you believe that you have mold toxicity, please consult with a mold-literate provider in your area: https://drcrista.com/doctor-finder/.

Customer Educational Handout
References
1. Mold Statistics 2024 – Black Mold in Homes 2024. Mychemicalfreehouse.org. Published July 1st, 2024. Accessed February 13th, 2025. https://www.mychemicalfreehouse.net/2024/07/mold-statistics-2024-black-mold-in-the-usa.html.
2. Mold Count by State 2024. Worldpopulationreview.com. Published 2024. Accessed February 15th, 2025. https://worldpopulationreview.com/state-rankings/mold-count-by-state.